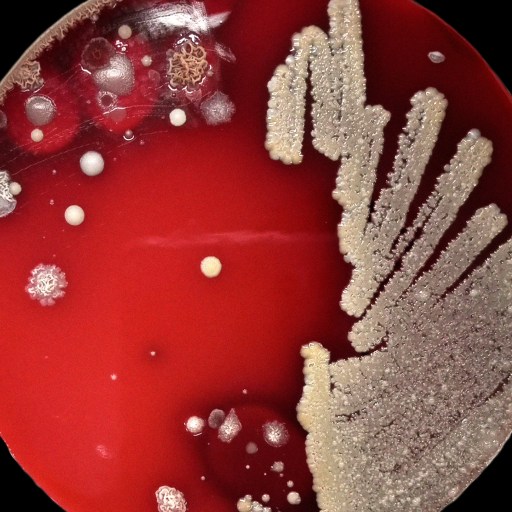
A petri dish with a red agar medium shows various colonies of bacteria growing, with dense streaks on the right and scattered colonies on the left.

Search
Intimate interviews with the world's biggest thinkers.
Latest episode
The solar revolution turning sunlight into synthetic fuel
“10 years ago, my colleagues and I looked at the prognosis for climate change, and it looked pretty hopeless. There really was no way out. But something happened – something good.”


25mins
"I continue to believe that in the long run, boys, young men will believe their eyes more than their ears."

22mins
"It's much better to try to understand how the world works and then act accordingly. Rather than trying to impose on the world the way we want to think or the way we preferred things to be."

25mins
"The big question then is why are most people resilient and why are some people not resilient?"

16mins
"Being connected to another person makes us feel safer and keeps our bodies at a kind of physiologic equilibrium that promotes health."

7mins
Members
“The problem with cognitive scripts is when we use them to make more important decisions in our lives, we let our choices be driven by those stories that we have internalized that tell us how we're supposed to behave in a certain situation.”

11mins
Members
“The next revolution will be quantum computers that will make the digital computer look like an abacus.”

15mins
“Until very recently, I thought I would die with the same genome that I was born with.”

8mins
“I've started to think about three puzzles we need to solve for as we bring these technologies into our organizations.”

13mins
“People got skeptical, fearful, doubtful of the very idea of progress in the 20th century and we allowed that to slow down progress itself.”

8mins
“The purpose of a coach is to not be the one to set the goals, but instead to say, "Here are the kinds of goals we can work our way through.””
13mins
“Chance invents and natural selection propagates that chance invention.”

16mins
“The messy reality of it is that all of these very smart people, including Isaac Newton, were talking to other people.”

10mins
“When you start to accept that you have profound influence on the world, but very limited control, you start to see the world differently.”

13mins
“Over the last 10 or 15 years, scientists have really started to understand the fundamental underlying biology of the aging process. And they broke this down into 12 hallmarks of aging.”

9mins
“There would be something very, very empty and meaningless about [a] sort of life with no problems.”

21mins
“The idea is that we move from a place of wanting the world to conform to what we like [towards] not needing other people to be different from who they are.”

15mins
"We're living in an extraordinary moment in history. We are at a moment here in 2025 where we have world historic game-changing technologies now starting to scale."

24mins
“Deep down the natural endpoint of this whole goal of looking for planets is to answer the question: are we alone?”

16mins
“No matter what their gods were, what they did for a living, what they wore, the songs they sang, everything varies except love, and everybody loves.”

9mins
“The universe clicks along in perfect accord with the laws of physics forever.”




















